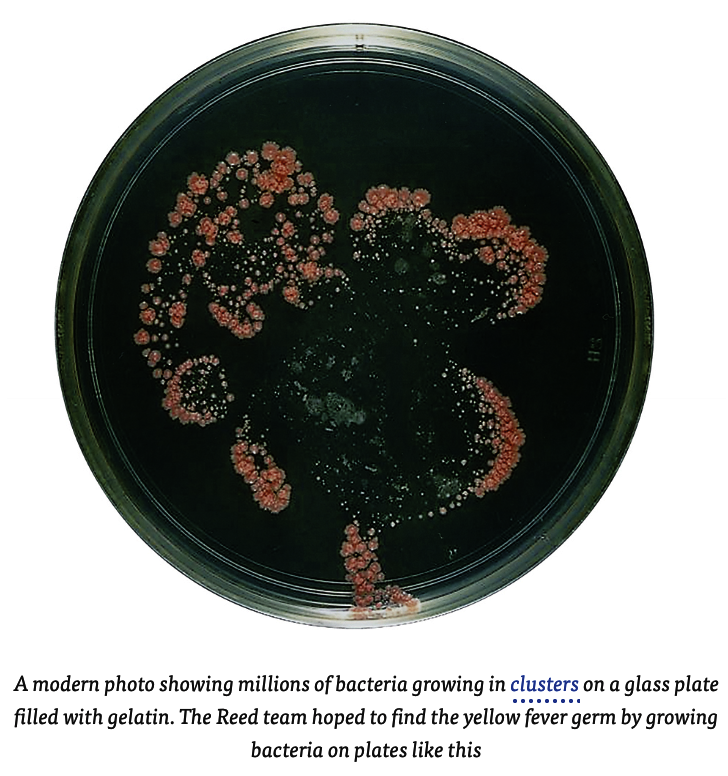

Excerpt from Chapter 3 in The Secret of the Yellow Death by Suzanne Jurmain
6 The first meeting had already been called, and late in the afternoon Reed walked onto the garden patio outside Camp Columbia’s Officers’ Quarters to greet the three men he’d be working with.
7 They were all there, formally dressed in their crisp white tropical army uniforms. On one side was the tall, thin, balding Dr. James Carroll, a blunt, outwardly charmless man who seemed to be more comfortable looking through a microscope than making conversation. Near Carroll was the chatty Cuban-born, U.S.-educated Dr. Aristides Agramonte, looking like a dandy with his pointed, curled mustache. And rounding out the group was the quiet, bearded, darkly handsome Dr. Jesse W. Lazear.
8 All of the men had graduated from medical school. All had studied bacteriology, and together they brought a wealth of talent to the project. Carroll had a real passion for lab work. Agramonte, an honors graduate of Columbia University Medical School, had already spent time investigating yellow fever. And Lazear, a former college football player who’d studied medicine in both the United States and Europe, had headed one of the clinical labs at America’s prestigious Johns Hopkins University. All three men had worked with Reed in the past, and they listened intently as the chief scientist outlined his program.
9 The first job, Reed told his colleagues, was to prove that Bacillus icteroides was—or was not—the cause of yellow fever.
10 That would take a lot of lab work, and each scientist would have his own specific job.
11 Agramonte would do autopsies. He’d surgically open the bodies of dead yellow fever victims and take out samples of blood, stomach, heart, kidney, and other organ tissues.
12 Carroll, the best bacteriologist, would take those samples to the lab. He would place tiny amounts of the tissue Agramonte harvested in tubes or dishes filled with a food substance like gelatin or bouillon. Then he would watch to see if any of the tissue samples grew Bacillus icteroides or any other bacteria that might prove to be the cause of yellow fever.
13 Lazear would help examine the bacteria and tissues under a microscope.
14 Reed would coordinate the work and help out wherever he could. That covered the important points. But there was one thing more. As he looked around at his assistants, Reed said that he hoped the group would stick closely to his plan. Finding the cause of yellow fever was a tremendous challenge, and he wanted the men to combine their efforts and attack the problem as a team.
15 Everyone agreed. Work was scheduled to start the following morning. And, as they left the meeting, the four men must have known they were about to start a very dangerous project. People who had had yellow fever were immune. They couldn’t possibly get the disease again. But none of the men on Reed’s team had ever had a full-blown attack of yellow fever. Reed had certainly never had the disease. Neither had Lazear or Carroll. Though there was a chance that the Cuban-born Agramonte might have had a very mild case as a small child, he was not definitely immune. And all four doctors knew that by being on the fever-stricken island of Cuba, by coming close to sick patients, and by studying bacteria in the lab, they were running a serious risk of getting yellow fever.